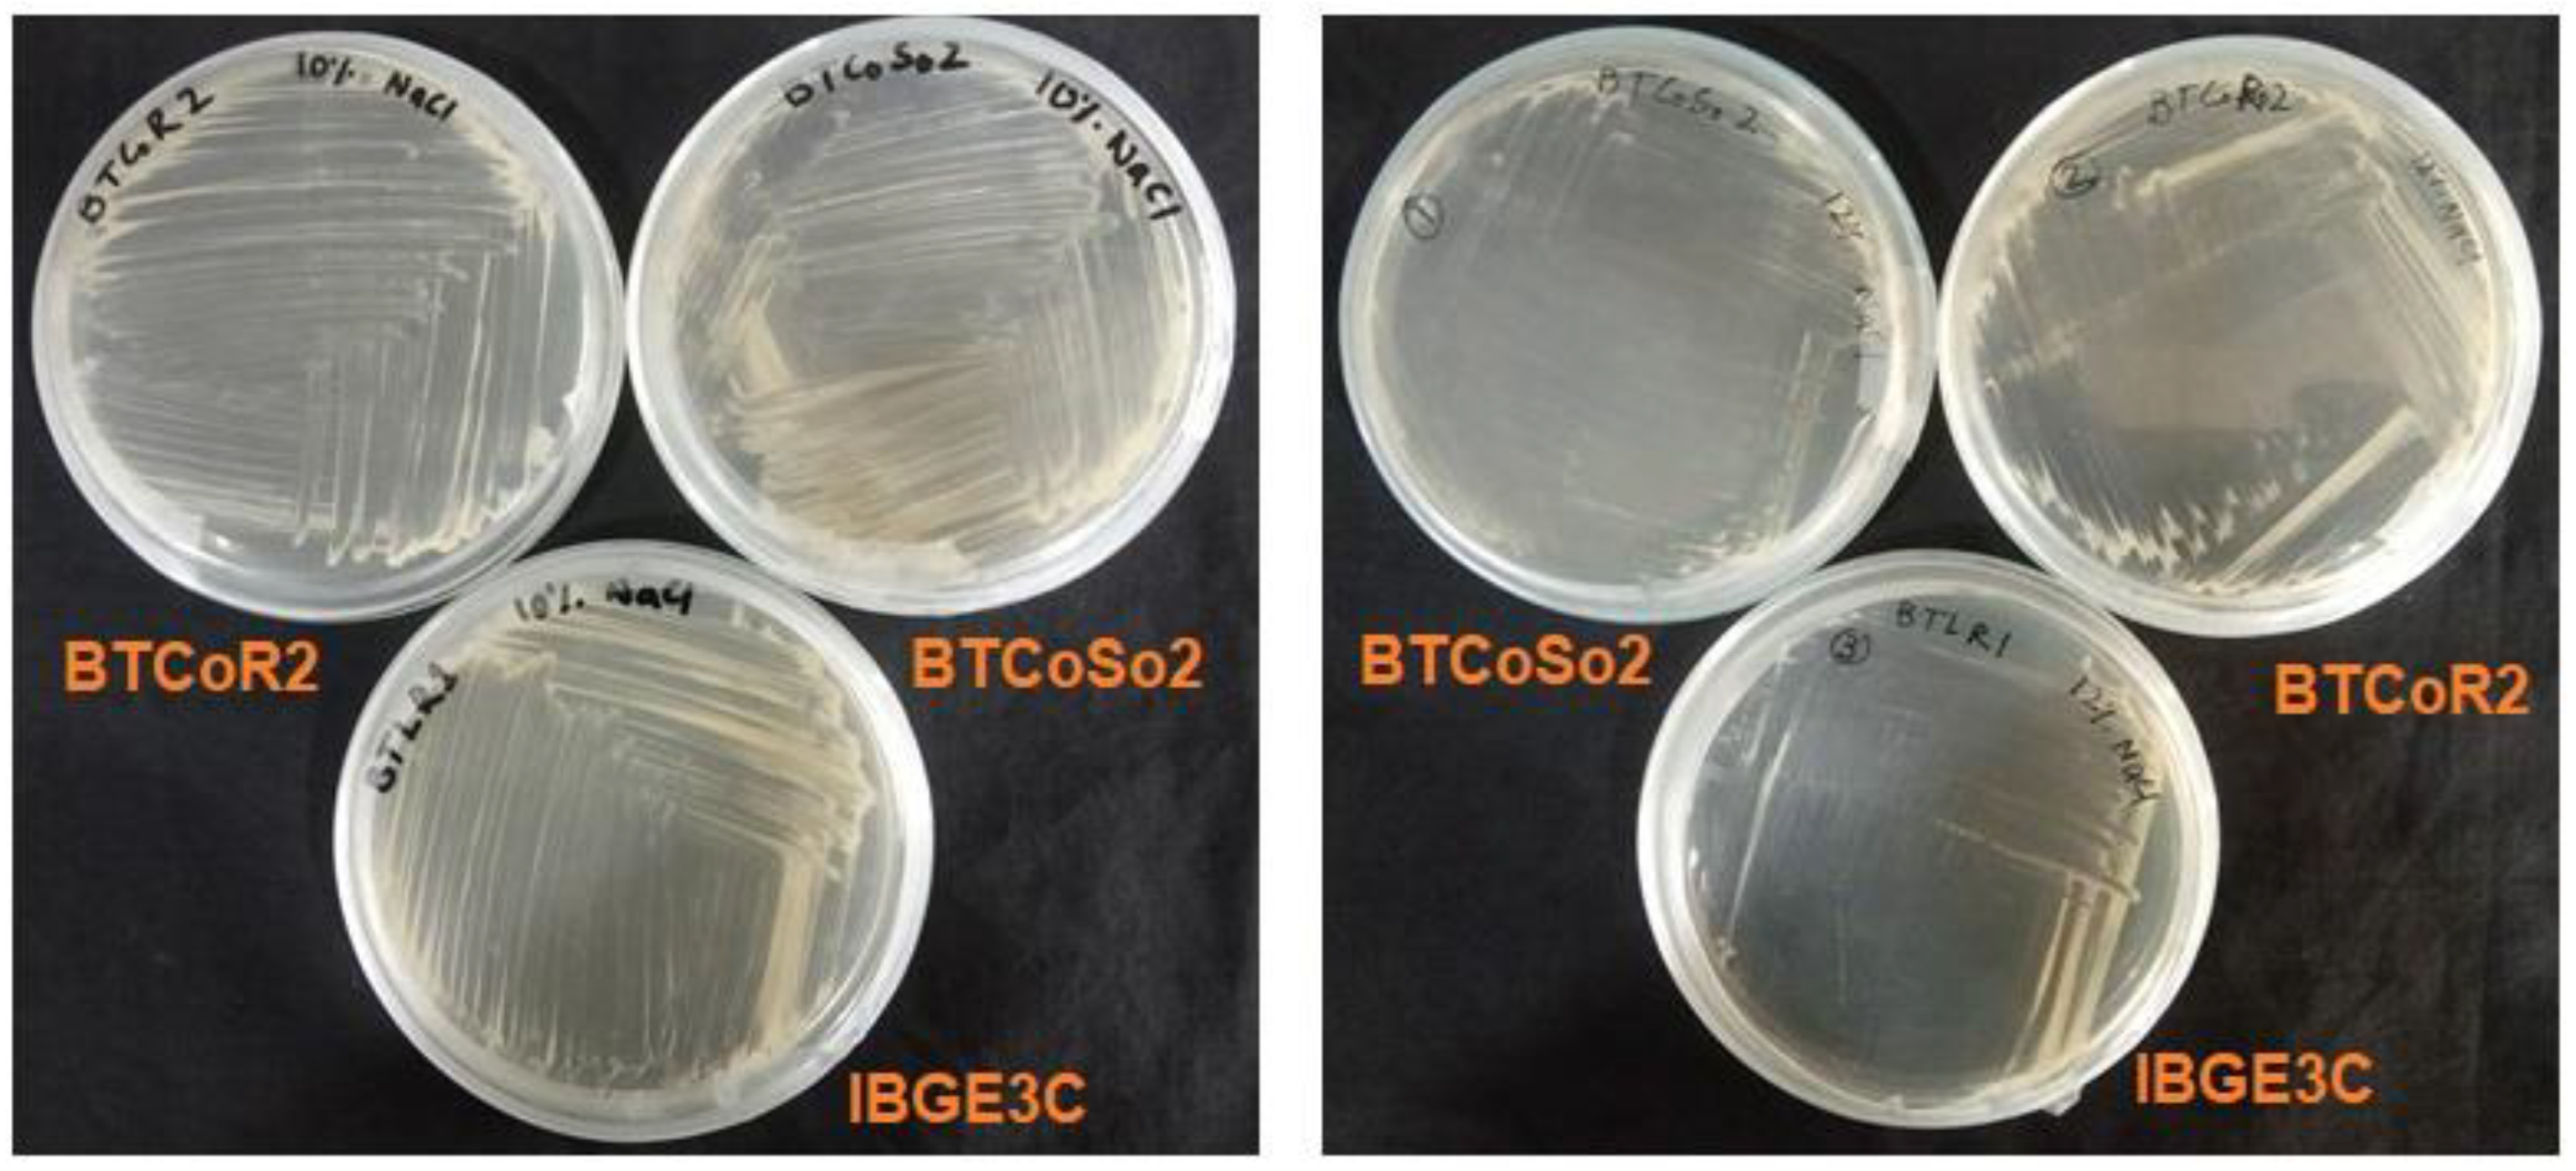
Stresses 02 00020 g003

A Highly Salt-Tolerant Bacterium Brevibacterium sediminis Promotes the Growth of Rice (Oryza sativa L.) Seedlings
Abstract
:1. Introduction
2. Results
2.1. Isolation and Screening of Salinity-Tolerant Bacteria
2.2. Effect of Bacterial Isolates on Vegetative Growth of BRRIdhan 29 Seedlings
2.3. Effect of Bacterial Isolates on Vegetative Growth of BINAdhan-10 Seedlings
2.4. Molecular Identification of the Most Salinity-Tolerant PGPB
3. Discussion
3.1. Isolation and Screening of the Bacterial Isolates
3.2. Effects of Bacterial Isolates on Rice Seedlings in Petri Dish
3.3. DNA Sequencing and Molecular Identification of the Best Performing Isolate IBGE3C
4. Materials and Methods
4.1. Plant Samples Collection
4.2. Isolation and Screening of Bacteria
4.3. Preparation of Bacterial Inocula
4.4. Seed Treatment with Bacteria
4.5. Seedling Assay
4.6. Genomic DNA Extraction, Ribosomal Gene (16S rRNA) Sequencing, and Data Analysis
4.7. Statistical Analysis
5. Conclusions
Author Contributions
Funding
Data Availability Statement
Acknowledgments
Conflicts of Interest
Abbreviations
| EC | Electrical conductivity |
| ECe | Electrical conductivity of the saturation extract |
| RPM | Rotation per minute |
| NaCl | Sodium chloride |
| KOH | Potassium hydroxide |
| SDW | Sterile distilled water |
| ACC | 1-aminocyclopropane-1-carboxylic acid |
| IAA | Indole-3-acetic acid |
| NBA | Nutrient broth agar |
| DNA | Deoxyribonucleic acid |
| RNA | Ribonucleic acid |
| PCR | Polymerase chain reaction |
| BINA | Bangladesh Institute of Nuclear Agriculture |
| BRRI | Bangladesh Rice Research Institute |
| IBGE | Institute of Biotechnology and Genetic Engineering |
| BSMRAU | Bangabandhu Sheikh Mujibur Rahman Agricultural University |
| NCBI | National Center for Biotechnology Information |
| BLAST | Basic Local Alignment Search Tool |
| ANOVA | Analysis of variance |
| LSD | Least Significant Difference |
References
- Zörb, C.; Geilfus, C.-M.; Dietz, K.-J. Salinity and Crop Yield. Plant Biol. 2019, 21, 31–38. [Google Scholar] [CrossRef] [PubMed]
- Gupta, A.; Mishra, R.; Rai, S.; Bano, A.; Pathak, N.; Fujita, M.; Kumar, M.; Hasanuzzaman, M. Mechanistic Insights of Plant Growth Promoting Bacteria Mediated Drought and Salt Stress Tolerance in Plants for Sustainable Agriculture. Int. J. Mol. Sci. 2022, 23, 3741. [Google Scholar] [CrossRef] [PubMed]
- Baten, M.A.; Seal, L.; Lisa, K.S. Salinity Intrusion in Interior Coast of Bangladesh: Challenges to Agriculture in South-Central Coastal Zone. Am. J. Clim. Chang. 2015, 4, 248. [Google Scholar] [CrossRef] [Green Version]
- Szabo, S.; Hossain, M.; Adger, W.N.; Matthews, Z.; Ahmed, S.; Lázár, A.N.; Ahmad, S. Soil Salinity, Household Wealth and Food Insecurity in Tropical Deltas: Evidence from South-West Coast of Bangladesh. Sustain. Sci. 2016, 11, 411–421. [Google Scholar] [CrossRef] [PubMed] [Green Version]
- Nawaz, A.; Farooq, M.; Nadeem, F.; Siddique, K.H.; Lal, R. Rice–Wheat Cropping Systems in South Asia: Issues, Options and Opportunities. Crop Pasture Sci. 2019, 70, 395–427. [Google Scholar] [CrossRef]
- Hasan, M.H.; Rahman, M.R.; Haque, A.; Hossain, T. Soil Salinity Hazard Assessment in Bangladesh Coastal Zone. In Proceedings of the International Conference on Disaster Risk Management, Dhaka, Bangladesh, 12–14 January 2019. [Google Scholar]
- Cominelli, E.; Conti, L.; Tonelli, C.; Galbiati, M. Challenges and Perspectives to Improve Crop Drought and Salinity Tolerance. New Biotechnol. 2013, 30, 355–361. [Google Scholar] [CrossRef]
- Visarada, K.; Meena, K.; Aruna, C.; Srujana, S.; Saikishore, N.; Seetharama, N. Transgenic Breeding: Perspectives and Prospects. Crop Sci. 2009, 49, 1555–1563. [Google Scholar] [CrossRef]
- Bradford, K.J.; Van Deynze, A.; Gutterson, N.; Parrott, W.; Strauss, S.H. Regulating Transgenic Crops Sensibly: Lessons from Plant Breeding, Biotechnology and Genomics. Nat. Biotechnol. 2005, 23, 439–444. [Google Scholar] [CrossRef]
- Chandler, S.F.; Sanchez, C. Genetic Modification; the Development of Transgenic Ornamental Plant Varieties. Plant Biotechnol. J. 2012, 10, 891–903. [Google Scholar] [CrossRef]
- Hossain, M.T.; Islam, T. Amelioration of Salinity Stress by Bacillus Species as Promoters of Plant Growth in Saline Soil. In Bacilli in Agrobiotechnology; Springer: Cham, Switzerland, 2022; pp. 199–208. [Google Scholar]
- Zalidis, G.; Stamatiadis, S.; Takavakoglou, V.; Eskridge, K.; Misopolinos, N. Impacts of Agricultural Practices on Soil and Water Quality in the Mediterranean Region and Proposed Assessment Methodology. Agric. Ecosyst. Environ. 2002, 88, 137–146. [Google Scholar] [CrossRef]
- Hassani, A.; Azapagic, A.; Shokri, N. Global Predictions of Primary Soil Salinization under Changing Climate in the 21st Century. Nat. Commun. 2021, 12, 6663. [Google Scholar] [CrossRef] [PubMed]
- Ayub, M.A.; Usman, M.; Faiz, T.; Umair, M.; Rizwan, M.; Ali, S.; Zia ur Rehman, M. Restoration of Degraded Soil for Sustainable Agriculture. In Soil Health Restoration and Management; Springer: Berlin/Heidelberg, Germany, 2020; pp. 31–81. [Google Scholar]
- Osman, K.T. Saline and Sodic Soils. In Management of Soil Problems; Springer: Berlin/Heidelberg, Germany, 2018; pp. 255–298. [Google Scholar]
- Shrivastava, P.; Kumar, R. Soil Salinity: A Serious Environmental Issue and Plant Growth Promoting Bacteria as One of the Tools for Its Alleviation. Saudi J. Biol. Sci. 2015, 22, 123–131. [Google Scholar] [CrossRef] [PubMed] [Green Version]
- dos Santos, T.B.; Ribas, A.F.; de Souza, S.G.H.; Budzinski, I.G.F.; Domingues, D.S. Physiological Responses to Drought, Salinity, and Heat Stress in Plants: A Review. Stresses 2022, 2, 113–135. [Google Scholar] [CrossRef]
- Egamberdieva, D.; Wirth, S.; Bellingrath-Kimura, S.D.; Mishra, J.; Arora, N.K. Salt-Tolerant Plant Growth Promoting Rhizobacteria for Enhancing Crop Productivity of Saline Soils. Front. Microbiol. 2019, 10, 2791. [Google Scholar] [CrossRef] [Green Version]
- Jamil, M.; Rha, E.-S. The Effect of Salinity (NaCl) on the Germination and Seedling of Sugar Beet (Beta Vulgaris L.) and Cabbage (Brassica Oleracea L.). Plant Resour. 2004, 7, 226–232. [Google Scholar]
- Ryan, C.A.; Jagendorf, A. Self Defense by Plants. Proc. Natl. Acad. Sci. USA 1995, 92, 4075. [Google Scholar] [CrossRef] [Green Version]
- Safdar, H.; Amin, A.; Shafiq, Y.; Ali, A.; Yasin, R.; Shoukat, A.; Hussan, M.U.; Sarwar, M.I. A Review: Impact of Salinity on Plant Growth. Nat. Sci. 2019, 17, 34–40. [Google Scholar]
- Islam, M.T.; Rahman, M.; Pandey, P.; Jha, C.K.; Aeron, A. Bacilli and Agrobiotechnology; Springer: Cham, Switzerland, 2016; Volume 6, pp. 47–87. [Google Scholar]
- Glick, B.R. Plant Growth-Promoting Bacteria: Mechanisms and Applications. Scientifica 2012, 2012, 963401. [Google Scholar] [CrossRef] [Green Version]
- Vessey, J.K. Plant Growth Promoting Rhizobacteria as Biofertilizers. Plant Soil 2003, 255, 571–586. [Google Scholar] [CrossRef]
- Lucy, M.; Reed, E.; Glick, B.R. Applications of Free Living Plant Growth-Promoting Rhizobacteria. Antonie Van Leeuwenhoek 2004, 86, 1–25. [Google Scholar] [CrossRef]
- Shelley, I.J.; Takahashi-Nosaka, M.; Kano-Nakata, M.; Haque, M.S.; Inukai, Y. Rice Cultivation in Bangladesh: Present Scenario, Problems, and Prospects. J. Int. Coop. Agric. Dev. 2016, 14, 20–29. [Google Scholar]
- Chowdhury, M.A. Sustainability of Accelerated Rice Production in Bangladesh: Technological Issues and the Environment. Bangladesh J. Agric. Res. 2009, 34, 523–529. [Google Scholar] [CrossRef] [Green Version]
- Khan, A.; Huda, F.A.; Alam, A. Farm Household Technical Efficiency: A Study on Rice Producers in Selected Areas of Jamalpur District in Bangladesh. Eur. J. Soc. Sci. 2010, 14, 262–271. [Google Scholar]
- Rahman, M.; Sabir, A.A.; Mukta, J.A.; Khan, M.; Alam, M.; Mohi-Ud-Din, M.; Miah, M.; Rahman, M.; Islam, M.T. Plant probiotic bacteria Bacillus and Paraburkholderia improve growth, yield and content of antioxidants in strawberry fruit. Sci. Rep. 2018, 8, 2504. [Google Scholar] [CrossRef] [Green Version]
- Kearl, J.; McNary, C.; Lowman, J.S.; Mei, C.; Aanderud, Z.T.; Smith, S.T.; West, J.; Colton, E.; Hamson, M.; Nielsen, B.L. Salt-Tolerant Halophyte Rhizosphere Bacteria Stimulate Growth of Alfalfa in Salty Soil. Front. Microbiol. 2019, 10, 1849. [Google Scholar] [CrossRef] [Green Version]
- Ansari, M.; Shekari, F.; Mohammadi, M.H.; Juhos, K.; Végvári, G.; Biró, B. Salt-Tolerant Plant Growth-Promoting Bacteria Enhanced Salinity Tolerance of Salt-Tolerant Alfalfa (Medicago Sativa L.) Cultivars at High Salinity. Acta Physiol. Plant. 2019, 41, 1–13. [Google Scholar] [CrossRef] [Green Version]
- Sharma, A.; Dev, K.; Sourirajan, A.; Choudhary, M. Isolation and Characterization of Salt-Tolerant Bacteria with Plant Growth-Promoting Activities from Saline Agricultural Fields of Haryana, India. J. Genet. Eng. Biotechnol. 2021, 19, 195. [Google Scholar] [CrossRef]
- Nakbanpote, W.; Panitlurtumpai, N.; Sangdee, A.; Sakulpone, N.; Sirisom, P.; Pimthong, A. Salt-Tolerant and Plant Growth-Promoting Bacteria Isolated from Zn/Cd Contaminated Soil: Identification and Effect on Rice under Saline Conditions. J. Plant Interact. 2014, 9, 379–387. [Google Scholar] [CrossRef] [Green Version]
- Shultana, R.; Kee Zuan, A.T.; Yusop, M.R.; Saud, H.M. Characterization of Salt-Tolerant Plant Growth-Promoting Rhizobacteria and the Effect on Growth and Yield of Saline-Affected Rice. PLoS ONE 2020, 15, e0238537. [Google Scholar] [CrossRef]
- Wang, R.; Wang, C.; Feng, Q.; Liou, R.-M.; Lin, Y.-F. Biological Inoculant of Salt-Tolerant Bacteria for Plant Growth Stimulation under Different Saline Soil Conditions. J. Microbiol. Biotechnol. 2021, 31, 398–407. [Google Scholar] [CrossRef]
- Chopra, A.; Vandana, U.K.; Rahi, P.; Satpute, S.; Mazumder, P.B. Plant Growth Promoting Potential of Brevibacterium Sediminis A6 Isolated from the Tea Rhizosphere of Assam, India. Biocatal. Agric. Biotechnol. 2020, 27, 101610. [Google Scholar] [CrossRef]
- Chen, P.; Zhang, L.; Wang, J.; Ruan, J.; Han, X.; Huang, Y. Brevibacterium Sediminis Sp. Nov., Isolated from Deep-Sea Sediments from the Carlsberg and Southwest Indian Ridges. Int. J. Syst. Evol. Microbiol. 2016, 66, 5268–5274. [Google Scholar] [CrossRef] [PubMed]
- Siddikee, M.A.; Chauhan, P.S.; Anandham, R.; Han, G.-H.; Sa, T.-M. Isolation, Characterization, and Use for Plant Growth Promotion under Salt Stress, of ACC Deaminase-Producing Halotolerant Bacteria Derived from Coastal Soil. J. Microbiol. Biotechnol. 2010, 20, 1577–1584. [Google Scholar] [CrossRef] [PubMed]
- Kumar, A.; Singh, S.; Gaurav, A.K.; Srivastava, S.; Verma, J.P. Plant Growth-Promoting Bacteria: Biological Tools for the Mitigation of Salinity Stress in Plants. Front. Microbiol. 2020, 11, 1216. [Google Scholar] [CrossRef] [PubMed]
- Chatterjee, P.; Samaddar, S.; Niinemets, Ü.; Sa, T.-M. Brevibacterium Linens RS16 Confers Salt Tolerance to Oryza Sativa Genotypes by Regulating Antioxidant Defense and H+ ATPase Activity. Microbiol. Res. 2018, 215, 89–101. [Google Scholar] [CrossRef] [PubMed]
- Sarker, A.; Ansary, M.; Rahman, W.; Hossain, M.N.; Islam, T. Prospect and challenges for sustainable management of climate change-associated stresses to soil and plant health by beneficial rhizobacteria. Stresses 2021, 1, 200–222. [Google Scholar] [CrossRef]
- Singh, R.P.; Jha, P.N. The Multifarious PGPR Serratia Marcescens CDP-13 Augments Induced Systemic Resistance and Enhanced Salinity Tolerance of Wheat (Triticum Aestivum L.). PLoS ONE 2016, 11, e0155026. [Google Scholar] [CrossRef] [Green Version]
- Vurukonda, S.S.K.P.; Vardharajula, S.; Shrivastava, M.; SkZ, A. Enhancement of Drought Stress Tolerance in Crops by Plant Growth Promoting Rhizobacteria. Microbiol. Res. 2016, 184, 13–24. [Google Scholar] [CrossRef]
- Belimov, A.A.; Dodd, I.C.; Safronova, V.I.; Hontzeas, N.; Davies, W.J. Pseudomonas Brassicacearum Strain Am3 Containing 1-Aminocyclopropane-1-Carboxylate Deaminase Can Show Both Pathogenic and Growth-Promoting Properties in Its Interaction with Tomato. J. Exp. Bot. 2007, 58, 1485–1495. [Google Scholar] [CrossRef] [Green Version]
- Kim, S.-Y.; Lim, J.-H.; Park, M.-R.; Kim, Y.-J.; Park, T.-I.; Seo, Y.-W.; Choi, K.-G.; Yun, S.-J. Enhanced Antioxidant Enzymes Are Associated with Reduced Hydrogen Peroxide in Barley Roots under Saline Stress. BMB Rep. 2005, 38, 218–224. [Google Scholar] [CrossRef] [Green Version]
- Qin, Y.; Druzhinina, I.S.; Pan, X.; Yuan, Z. Microbially Mediated Plant Salt Tolerance and Microbiome-Based Solutions for Saline Agriculture. Biotechnol. Adv. 2016, 34, 1245–1259. [Google Scholar] [CrossRef] [PubMed]
- Dame, Z.T.; Rahman, M.; Islam, T. Bacilli as sources of agrobiotechnology: Recent advances and future directions. Green Chem. Lett. Rev. 2021, 14, 246–271. [Google Scholar] [CrossRef]
- Kang, S.-M.; Khan, A.L.; Waqas, M.; You, Y.-H.; Kim, J.-H.; Kim, J.-G.; Hamayun, M.; Lee, I.-J. Plant Growth-Promoting Rhizobacteria Reduce Adverse Effects of Salinity and Osmotic Stress by Regulating Phytohormones and Antioxidants in Cucumis Sativus. J. Plant Interact. 2014, 9, 673–682. [Google Scholar] [CrossRef] [Green Version]
- Del Amor, F.M.; Cuadra-Crespo, P. Plant Growth-Promoting Bacteria as a Tool to Improve Salinity Tolerance in Sweet Pepper. Funct. Plant Biol. 2011, 39, 82–90. [Google Scholar] [CrossRef] [PubMed]
- Onda, Y.; Kato, H.; Hoshi, M.; Takahashi, Y.; Nguyen, M.-L. Soil Sampling and Analytical Strategies for Mapping Fallout in Nuclear Emergencies Based on the Fukushima Dai-Ichi Nuclear Power Plant Accident. J. Environ. Radioact. 2015, 139, 300–307. [Google Scholar] [CrossRef]
- Mukta, J.A.; Rahman, M.; Sabir, A.A.; Gupta, D.R.; Surovy, M.Z.; Rahman, M.; Islam, M.T. Chitosan and plant probiotics application enhance growth and yield of strawberry. Biocatal. Agric. Biotechnol. 2017, 11, 9–18. [Google Scholar] [CrossRef]
- Anjum, N.; Chandra, R. Endophytic Bacteria: Optimization of Isolation Procedure from Various Medicinal Plants and Their Preliminary Characterization. Asian J. Pharm. Clin. Res. 2015, 8, 233–238. [Google Scholar]
- Arthi, K.; Appalaraju, B.; Parvathi, S. Vancomycin Sensitivity and KOH String Test as an Alternative to Gram Staining of Bacteria. Indian J. Med. Microbiol. 2003, 21, 121–123. [Google Scholar] [CrossRef]
- Khan, M.M.A.; Haque, E.; Paul, N.C.; Khaleque, M.A.; Al-Garni, S.M.; Rahman, M.; Islam, M.T. Enhancement of growth and grain yield of rice in nutrient deficient soils by rice probiotic bacteria. Rice Sci. 2017, 24, 264–273. [Google Scholar] [CrossRef]
- Sarkar, A.; Islam, T.; Biswas, G.C.; Alam, S.; Hossain, M.; Talukder, N.M. Screening for phosphate solubilizing bacteria inhabiting the rhizoplane of rice grown in acidic soil in Bangladesh. Acta Microbiol. Immunol. Hung. 2012, 59, 199–213. [Google Scholar] [CrossRef]
- Islam, M.T.; Deora, A.; Hashidoko, Y.; Rahman, A.; Ito, T.; Tahara, S. Isolation and identification of potential phosphate solubilizing bacteria from the rhizoplane of Oryza sativa L. cv. BR29 of Bangladesh. Z. Naturforsch. 2007, 62c, 103–110. [Google Scholar] [CrossRef] [PubMed]
- Islam, M.T.; Hasidoko, Y.; Deora, A.; Ito, T.; Tahara, S. Suppression of damping-off disease in host plants by the rhizoplane bacterium Lysobacter sp. strain SB-K88 is linked to plant colonization and antibiosis against soilborne Peronosporomycetes. Appl. Environ. Microbiol. 2005, 71, 3786–3796. [Google Scholar] [CrossRef] [PubMed] [Green Version]
- Hoque, M.N.; Istiaq, A.; Clement, R.A.; Gibson, K.M.; Saha, O.; Islam, O.K.; Abir, R.A.; Sultana, M.; Siddiki, A.Z.; Crandall, K.A.; et al. Insights into the resistome of bovine clinical mastitis microbiome, a key factor in disease complication. Front. Microbiol. 2020, 11, 860. [Google Scholar] [CrossRef] [PubMed]
- Kumar, S.; Stecher, G.; Tamura, K. MEGA7: Molecular evolutionary genetics analysis version 7.0 for bigger datasets. Mol. Biol. Evol. 2016, 33, 1870–1874. [Google Scholar] [CrossRef] [Green Version]
- Rahman, M.S.; Hoque, M.N.; Puspo, J.A.; Islam, M.R.; Das, N.; Siddique, M.A.; Hossain, M.A.; Sultana, M. Microbiome signature and diversity regulates the level of energy production under anaerobic condition. Sci. Rep. 2021, 11, 19777. [Google Scholar] [CrossRef]
- Letunic, I.; Bork, P. Interactive Tree of Life (iTOL) v4: Recent updates and new developments. Nucleic Acids Res. 2019, 47, W256–W259. [Google Scholar] [CrossRef] [Green Version]

| Name of Isolates | % NaCl Concentration (w/v) | ||||||
|---|---|---|---|---|---|---|---|
| Control | 2% | 4% | 6% | 8% | 10% | 12% | |
| BTNSo1 | +++ | +++ | +++ | ++ | NG | NG | NG |
| BTNSo2 | +++ | ++ | +++ | +++ | NG | NG | NG |
| BTNSo3 | +++ | +++ | +++ | +++ | NG | NG | NG |
| BTNSo4 | +++ | + | + | ++ | NG | NG | NG |
| BTNSo5 | +++ | +++ | +++ | +++ | ++ | ++ | + |
| BTNSo6 | +++ | +++ | +++ | +++ | NG | NG | NG |
| BTNSo7 | +++ | +++ | +++ | +++ | NG | NG | NG |
| BTNSo8 | +++ | ++ | ++ | + | NG | NG | NG |
| BTCoR1 | +++ | +++ | + | + | NG | NG | NG |
| BTCoR2 | +++ | +++ | +++ | ++ | +++ | ++ | ++ |
| BTCoR3 | +++ | ++ | +++ | +++ | +++ | ++ | + |
| BTCoR4 | +++ | +++ | +++ | +++ | + | NG | NG |
| BTCoL1 | +++ | +++ | +++ | +++ | +++ | + | NG |
| BTCoL2 | +++ | +++ | +++ | +++ | +++ | + | NG |
| BTCoL3 | +++ | +++ | +++ | ++ | ++ | + | NG |
| BTCoL4 | +++ | +++ | ++ | + | NG | NG | NG |
| BTCoL5 | +++ | +++ | ++ | ++ | +++ | + | NG |
| BTCoL6 | +++ | +++ | +++ | + | ++ | + | NG |
| BTCoSo1 | +++ | +++ | +++ | + | + | NG | NG |
| BTCoSo2 | +++ | +++ | +++ | +++ | +++ | +++ | ++ |
| BTCoSo3 | +++ | +++ | +++ | +++ | NG | NG | NG |
| BTCoSo4 | +++ | +++ | +++ | + | + | NG | NG |
| BTCoSo5 | +++ | +++ | +++ | + | NG | NG | NG |
| BTCoSo6 | +++ | +++ | +++ | + | NG | NG | NG |
| BTChL1 | +++ | +++ | +++ | +++ | +++ | + | NG |
| BTChL2 | +++ | +++ | +++ | +++ | +++ | + | NG |
| BTChR1 | +++ | +++ | ++ | + | + | NG | NG |
| BTChR2 | +++ | +++ | +++ | ++ | ++ | + | NG |
| BTChSo1 | +++ | +++ | +++ | +++ | NG | NG | NG |
| BTChSo2 | +++ | +++ | +++ | ++ | NG | NG | NG |
| BTLSo1 | +++ | +++ | ++ | + | NG | NG | NG |
| BTLSo2 | +++ | +++ | +++ | + | NG | NG | NG |
| BTLSo3 | +++ | +++ | +++ | ++ | NG | NG | NG |
| BTLSo4 | +++ | +++ | +++ | +++ | NG | NG | NG |
| BTLSo5 | +++ | +++ | +++ | ++ | NG | NG | NG |
| BTLSo6 | +++ | +++ | +++ | ++ | NG | NG | NG |
| BTLSo7 | +++ | +++ | +++ | ++ | + | NG | NG |
| BTLSo8 | +++ | ++ | +++ | +++ | + | NG | NG |
| BTLSo9 | +++ | +++ | +++ | ++ | + | NG | NG |
| BTLSo10 | +++ | +++ | +++ | +++ | ++ | ++ | + |
| IBGE3C | +++ | ++ | +++ | +++ | +++ | +++ | ++ |
| Treatment | Seedling Growth * | |||
|---|---|---|---|---|
| Root Length (cm) | Shoot Length (cm) | Root Dry Weight (mg) | Shoot Dry Weight (mg) | |
| Control | 0.87 ± 0.03 c | 1.23 ± 0.03 c | 3.23 ± 0.07 d | 5.4 ± 0.29 d |
| BTCoSo2 | 1.27 ± 0.09 b | 1.9 ± 0.12 ab | 6.4 ± 0.36 c | 7.33 ± 0.22 b |
| BTCoR2 | 1.7 ± 0.06 a | 1.83 ± 0.09 b | 7.53 ± 0.33 b | 8.43 ± 0.27 c |
| IBGE3C | 0.93 ± 0.09 c | 2 ± 0.12 a | 10.93 ± 1.02 a | 11.2 ±0.15 a |
| Treatment | Seedling Growth * | |||
|---|---|---|---|---|
| Root Length (cm) | Shoot Length (cm) | Root Dry Weight (mg) | Shoot Dry Weight (mg) | |
| Control | 1.93 ± 0.09 b | 2.23 ± 0.07 b | 10.83 ± 0.09 c | 13.33 ± 0.23 b |
| BTCoSo2 | 2.03 ± 0.12 ab | 2.33 ± 0.12 a | 13.93 ± 0.09 b | 14.23 ± 0.18 ab |
| BTCoR2 | 2.2 ± 0.15 a | 2.43 ± 0.07 a | 11.2 ± 0.15 b | 12.3 ± 0.21 ab |
| IBGE3C | 2.8 ± 0.10 ab | 2.93 ± 0.09 a | 13.97 ± 0.12 a | 12.27 ± 0.20 a |
Publisher’s Note: MDPI stays neutral with regard to jurisdictional claims in published maps and institutional affiliations. |
© 2022 by the authors. Licensee MDPI, Basel, Switzerland. This article is an open access article distributed under the terms and conditions of the Creative Commons Attribution (CC BY) license (https://creativecommons.org/licenses/by/4.0/).
Share and Cite
Mahmud-Ur-Rahman; Naser, I.B.; Mahmud, N.U.; Sarker, A.; Hoque, M.N.; Islam, T. A Highly Salt-Tolerant Bacterium Brevibacterium sediminis Promotes the Growth of Rice (Oryza sativa L.) Seedlings. Stresses 2022, 2, 275-289. https://doi.org/10.3390/stresses2030020
Mahmud-Ur-Rahman, Naser IB, Mahmud NU, Sarker A, Hoque MN, Islam T. A Highly Salt-Tolerant Bacterium Brevibacterium sediminis Promotes the Growth of Rice (Oryza sativa L.) Seedlings. Stresses. 2022; 2(3):275-289. https://doi.org/10.3390/stresses2030020
Chicago/Turabian StyleMahmud-Ur-Rahman, Iftekhar Bin Naser, Nur Uddin Mahmud, Aniruddha Sarker, M. Nazmul Hoque, and Tofazzal Islam. 2022. "A Highly Salt-Tolerant Bacterium Brevibacterium sediminis Promotes the Growth of Rice (Oryza sativa L.) Seedlings" Stresses 2, no. 3: 275-289. https://doi.org/10.3390/stresses2030020
APA StyleMahmud-Ur-Rahman, Naser, I. B., Mahmud, N. U., Sarker, A., Hoque, M. N., & Islam, T. (2022). A Highly Salt-Tolerant Bacterium Brevibacterium sediminis Promotes the Growth of Rice (Oryza sativa L.) Seedlings. Stresses, 2(3), 275-289. https://doi.org/10.3390/stresses2030020









